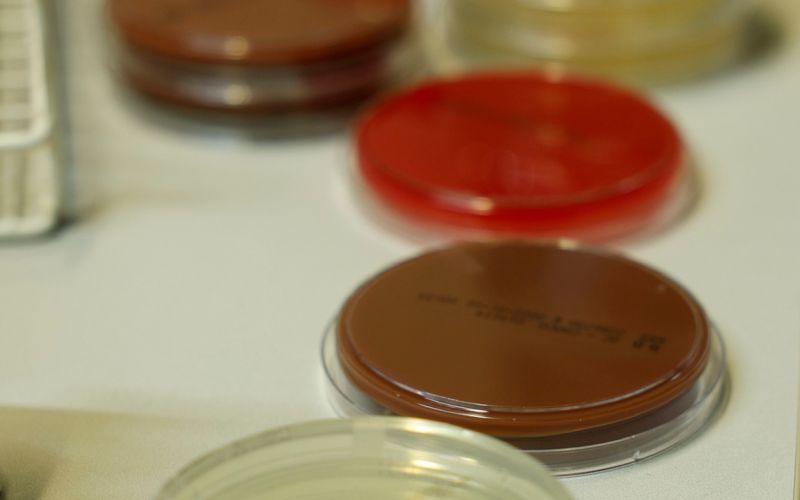

Herzlich willkommen auf den Internetseiten des Labors Blenk!
Wir sind ein hochspezialisiertes mikrobiologisch-infektionsserologisches Labor in Nürnberg und bieten seit über 35 Jahren unsere Leistungen zur infektiologischen Diagnostik für Ärzte aller Fachrichtungen in Nürnberg und Umgebung an.
Neben einer modernen Labordiagnostik ist uns der persönliche Kontakt sehr wichtig. Wir stehen Ihnen zu allen Fragen der Infektionsdiagnostik jederzeit zur Verfügung.
Seit der Gründung des Labors bieten wir eine Patientensprechstunde an. Unsere Praxis befindet sich im Metropol Medical Center Nürnberg